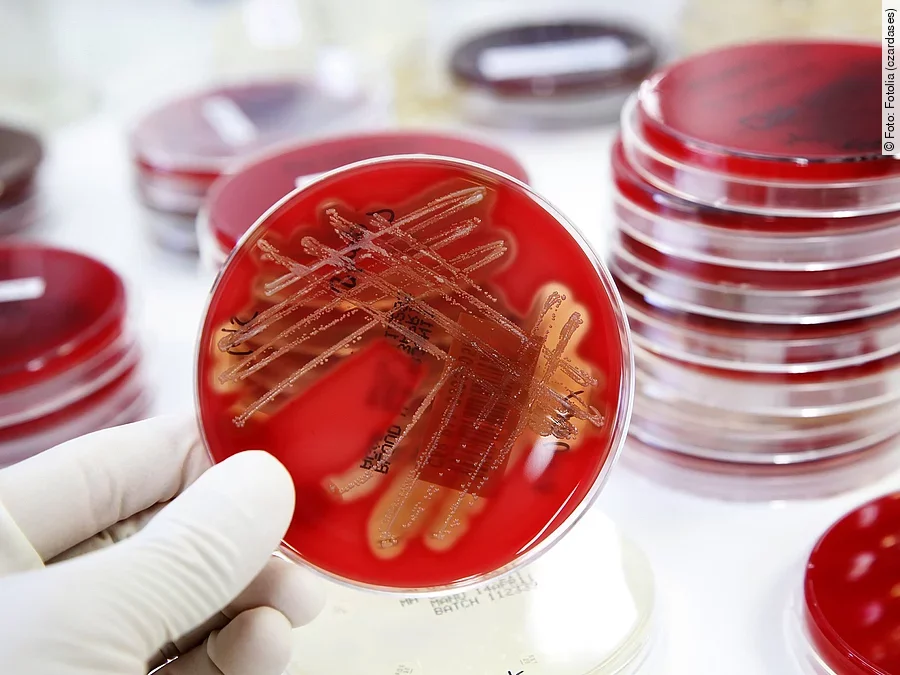
Bakterien

Sie werde derzeit nur „selektiv belegt“, damit zusätzliche Hygienemaßnahmen wie die Desinfektionen aller Flächen vorgenommen werden könnten, teilte das Klinikum am Freitag auf Anfrage mit.
„Im Klinikum Friedrichshafen kam es in den vergangenen Tagen zu einer unerwarteten Häufung von Kolonisationen mit Vancomycin-resistenten Enterokokken (VRE)“, erklärte Pressesprecherin Susann Ganzert. Die betroffenen Patienten seien umgehend isoliert worden. „Eine Infektion lag in keinem der drei Fälle vor.“ Anders als die internistische sei die chirurgische Intensivstation des Klinikums nicht betroffen.
Die Klinikleitung und das Gesundheitsamt des Bodenseekreises stimmen sich laut Mitteilung eng ab. „Die Entscheidung darüber, wann die internistische Intensivstation wieder «normal» laufen wird, liegt bei der Hygienekommission des Klinikums.“
Laut Weltgesundheitsorganisation (WHO) nehmen Keime, die gegen Antibiotika resistent sind, immer mehr zu. Allein in der EU sterben nach Angaben des Europäischen Zentrums für die Prävention und die Kontrolle von Krankheiten jährlich etwa 25 000 Menschen wegen einer Infektion mit Erregern, gegen die Antibiotika nicht mehr wirken.





Derzeit sind noch keine Kommentare vorhanden. Schreiben Sie den ersten Kommentar!
Jetzt einloggen